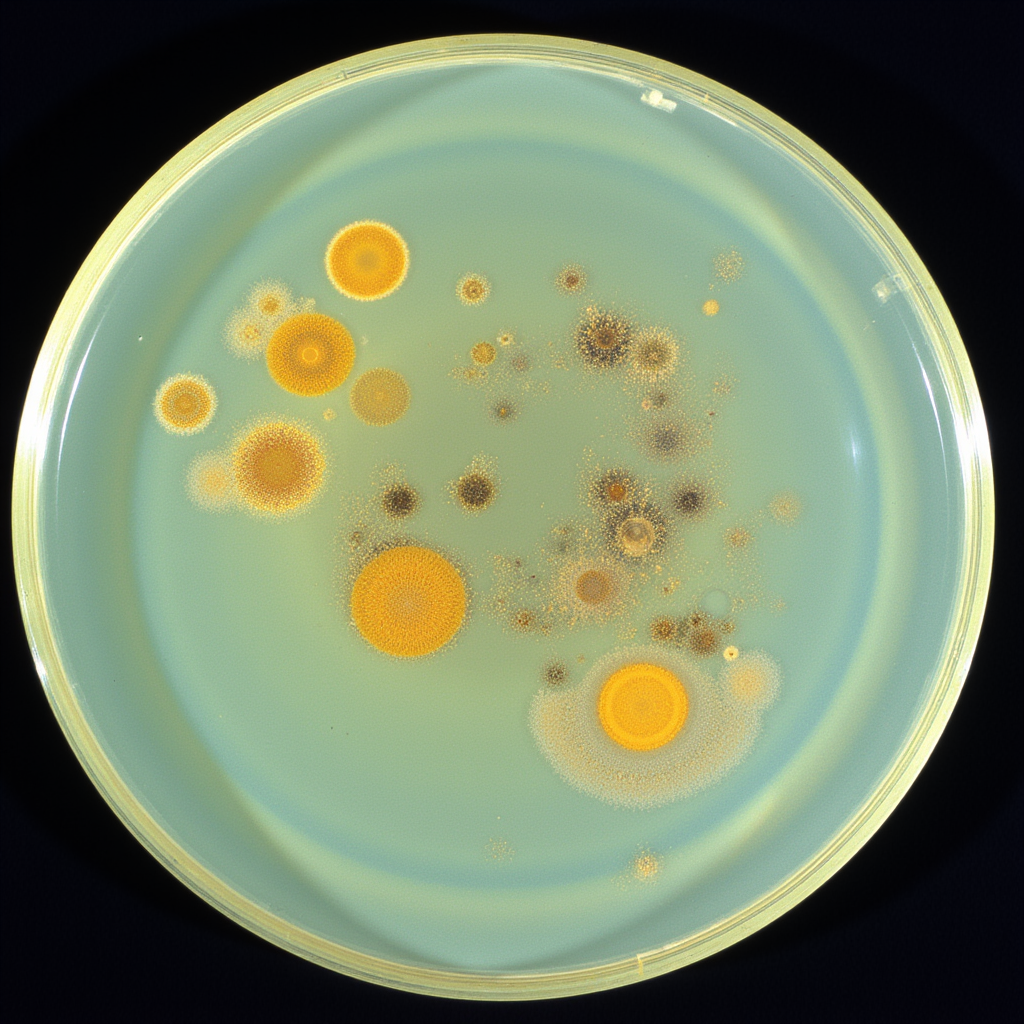

susi gutsche
about
Susi Gutsche is a research-driven artist with a background in Social Design – Arts as Urban Innovation, humanities, and scientific laboratory work. She participated in archaeological excavations, worked in clinical research settings, and collaborated with research institutions, integrating scientific methods into her artistic experiments.
Her work explores the intersection of art and everyday life, routines, and their aesthetics, addressing societal and environmental processes (in urban contexts). Through an experimental approach, she engages with multiple media, combining video, photography, participatory actions, unconventional materials and technologies. Currently she is especially interested in visual ruptures and non-smooth aesthetics.
Portfolio & cv